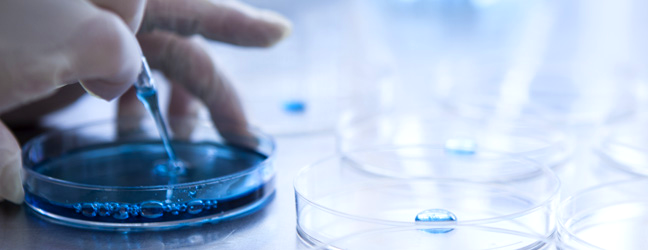

해외여행을 가기 위해서는 공항에서 출국심사 중 보안검색을 하는데 이에 대한 기본정보와 유의사항을 상세히 소개하려 합니다.

출국 전 보안검색 시 가장 많이 주의해야 하고, 많이 알아야 할 기본정보들로 정리를 해 보았습니다.
해외여행 가기 전에 부담 없이 읽어보고 유의해야 할 사항들을 인지하시고 가신다면 훨씬 출국하기 좋으실 거 같습니다.
자! 본격적으로 출국심사 전 보안검색에 대해 알아야 할 기본정보와 유의사항을 알아볼까요?

1. 종합 보안검색 유의사항
Comprehensive security search precautions

보안검색 전 휴대반입 제한물품을 종합적으로 안내하려 합니다.
출국 시 다음의 안내사항을 꼭 확인하여 주시기 바랍니다.
1. 기내반입 금지물품
- 무기로 사용될 수 있는 도검류(칼 등), 공구류, 스포츠 용품 및 폭발성, 인화성물품
(단, 날길이 6cm 이하 가위, 총길이 10cm 이하 렌치, 스패너는 기내반입 가능)
※ 맥가이버칼, 문구용 칼, 날길이 6cm 초과 가위 등은 휴대하여 기내에 반입할 수 없으니, 체크인카운터에서 부치는 짐(위탁수하물)으로 처리해야 합니다.
2. 허용량까지만 반입물품
- 물, 음료수, 김치, 된장/고추장, 스킨/로션/크림, 치약, 젤, 샴푸, 스프레이 등의 액체, 젤, 에어로졸의 경우도 허용량 외에 휴대반입이 제한됩니다.
※ 꼭 미리 허용량을 확인하시고 짐을 챙기시기 바랍니다.

2. 액체 및 젤류에 관한 기내소지 제한규정
Restrictions on carrying liquids and gels on board

인천국제공항에서 출발하는 국제선 모든 항공편을 대상으로 액체 분무 겔류에 해당하는 제품에 대하여 용량에 따라 객실 반입을 제한하고 있습니다.
▶ 액체 분무 겔류에 해당하는 제품을 기내로 가지고 가시려면
: 100ml 이하(내용물의 잔여량에 관계없이 개별 용기 용량 기준)+1L의 투명 지퍼백(20.5cm*20.5cm / 15cm*25cm)에 넣어 닫은 상태로 1인당 지퍼백 1개만 기내 소지가 가능합니다.
: 아래와 같이 유의사례와 대응방법을 실행해 보세요.
1) 기내 소지에 유의해야 하는 제품의 예
- 액체류 : 김치, 술, 생수, 음료수, 주스, 향수 등
- 분무류 : 헤어스프레이, 산소 스프레이, 몸에 뿌리는 해충 기피제 등
- 젤류 : 세면용품(치약, 샴푸 등), 젤 형태의 화장품(로션 등), 액체가 포함되어 있거나 젤 형태의 음식물류(고추장, 된장, 통조림 등)
※ 고체 형태의 밑반찬의 경우 기내로 가지고 갈 수 있습니다. (예 : 오징어채, 마른 멸치 등)
2) 지퍼백을 준비하지 못했을 경우
미리 준비를 하지 못하셨다면 제1여객터미널 및 제2여객터미널 3층 편의점에서 구입이 가능합니다.
3) 어린아이가 사용할 우유, 이유식 등
어린아이(만 6세 이하)를 동반한 승객이 휴대한 어린아이의 용품(우유, 물, 주스, 액체 젤 죽 형태의 음식 및 물티슈 등)은 비행여정 중 사용할 분량에 한하여 기내 소지를 허용하고 있습니다.

3. 향수, 스킨, 로션 등 화장품 및 개인위생용품(스프레이류) 보안검색
Security search for cosmetics and personal hygiene products (sprays) such as perfume, skin, lotion, etc.

▶ 향수, 스킨, 로션 등 화장품류의 액체 및 젤류 기내 반입 충족조건은 아래와 같습니다.
1) 각 용기당 100ml 이하
- 승객 1인당 1개만 허용되는 1L 규격의 투명 지퍼백 (20.5cm*20.5cm / 15cm*25cm) 안에 보관하여 지퍼를 잠근 상태여야 합니다.
※ 비닐이 완전히 잠겨 있지 않으면 기내 반입이 불가능
- 보안검색을 받기 전, 다른 짐과 분리하여 검색요원에게 제시
2) 스프레이로 된 개인위생용품은(헤어스프레이, 산소 스프레이, 몸에 뿌리는 해충 기피제 등) 100ml 이하
- 휴대수하물로 소지가 가능,
- 위탁수하물로는 2KG 범위 내에서 종류당 각 1개씩(500ml 이하) 처리 가능.
- 호신용 스프레이류는 객실 반입이 금지
: 위탁수하물에 한하여 인당 100ml 이하(내용물의 잔여량에 관계없이 개별 용기 용량 기준) 1개 반입 가능
- 인화성 살충제(에프킬라 등)는 객실, 위탁수하물 모두 반입 불가

4. 컴퓨터, MP3, 캠코더 등 전자제품(건전지 포함) 관한 보안검색
Security search for electronic products (including batteries) such as computers, MP3 players, camcorders, etc.

▶ 컴퓨터(PC, 노트북), MP3 등 항공기 안전에 무해한 전자제품은 휴대 및 위탁 수하물 처리가능
- 노트북 소지 후 보안검색 시에는 사전에 분리하여 바구니에 담아주시면 신속한 보안검색을 받으실 수 있습니다.
- 알카라인 종류의 배터리에 대해서는 휴대 수하물 및 위탁 수하물 처리 가능
- 리튬배터리인 경우는 제품의 포함된 것 외에 여유분 2개까지(100wh이하)는 가능
※ 습식배터리(전해액이 들어있는 축전지)는 항공기 탑재가 금지되는 점 유의

5. 한약, 홍삼 등 건강보조식품 및 음식물 반입 문의
Inquiries about bringing in health supplements and food such as herbal medicine and red ginseng

▶ 한약, 홍삼 등 건강보조식품류는 고체(알약, 가루포함) 일 경우
- 휴대수하물 또는 위탁수하물 처리 시 용량 제한 없습니다.
- 다만, 액체일 경우 100ml 초과 시 액체 및 젤류 규정에 따라 위탁수하물로 처리 가능합니다.
- 고체형태의 음식류는 위탁수하물(부치는 짐), 휴대수하물(가져가는 짐)로 처리 가능합니다.
※ 액체 및 젤류 타입의 음식(고추장, 김치, 된장 등) 100ml 초과 시 위탁수하물로 처리

6. 공항 내 면세물품 관한 문의
Inquiries regarding duty-free items at the airport

▶ 공항 내 면세점에서 물품을 구입한 경우
- 공항 면세점에서 전달받은 주류, 화장품 등의 액체류는 아래 조건을 모두 준수하는 경우 액체 및 젤류에 대한 규정이 적용되지 않으며 기내 반입이 가능.
- 면세점에서 제공하는 투명봉인봉투 또는 국제표준방식으로 제조된 훼손탐지가능봉투(STEB : Security Tamper Evident Bag)로 포장된 상태로, 면세품 구입당시 교부받은 영수증이 훼손탐지가능봉투 안에 동봉 또는 부착된 경우에 한하여 용량에 관계없이 반입 가능.
- 최종 목적지행 항공기 탑승 전까지 미개봉 상태를 유지
※ 해외 공항 환승 시, 보안규정이 상이하여 휴대한 액체류 물품에 대하여 포기/압수 절차를 따라야 할 경우가 발생할 수 있으니 해당국가의 환승객 보안규정에 대해 이용하시는 항공사 또는 여행사에 사전에 문의하시기 바랍니다.

7. 보안검색 중 포기물품에 관한 문의
Inquiry regarding abandoned items during security screening

▶ 기내반입 제한 물품뿐 아니라, 액체 및 젤류 등 제한 규정을 초과하여 물품을 포기하신 경우 해당 물품을 찾는 것이 불가합니다.
- 이점 꼭 유의 바라며, 출국 시 기내반입 금지물품이 무엇인지 꼭 확인해 보신 후 보안검색을 받으시기 바랍니다.

8. 가발 착용, 임산부 등 보안검색절차 문의
Inquiries about security screening procedures for wearing wigs, pregnant women, etc.

▶ 인천국제공항의 검색장비(문형 검색대, 원형 검색대, 휴대용 금속탐지기)에서 발생되는 자기장은 극소량으로, 인체에 무해합니다.
- 가발 착용, 임산부, 심리적 요소 등으로 인해 검색대 통과를 원하지 않을 경우 별도의 검색방법으로 보안검색 가능
- 수술 등의 이유로 신체 내부에 금속이 있을 경우 검색대 통과 시 경보가 울릴 수 있습니다
: 보안검색대를 통과하기 전에 미리 검색요원에게 수술 사실을 알려주시면 감안하여 별도의 방법으로 보안검색 가능

9. 인슐린과 주사기 및 약품에 관한 문의
Inquiries about insulin, syringes and medications

▶ 주사기, 침류 등 의료용 물품(도구)은 객실 및 위탁수하물 모두 반입이 가능합니다.
- 100ml를 초과하는 인슐린(액체 의약품)을 기내에 반입 시 의사 소견서 또는 처방전(국문 또는 영문)을 지참 필요
- 기내에서 사용하실 만큼의 양만을 휴대반입가능
: 여분의 인슐린(액체 의약품)은 위탁수하물(부치는 짐)로 보내셔야 하므로 이점 꼭 유의
- 처방전 등이 없는 경우에는 액체 및 젤류 반입제한 규정에 따라 100ml 이하만 기내반입이 가능.
※ 일부 물품은 보호케이스에 담겨있는 경우만 반입이 가능할 수도 있으며, 위험가능 물품은 반입이 제한될 수도 있습니다.

10. 폭죽, 가스 및 가스용기에 관한 문의
Inquiries regarding fireworks, gas and gas containers

▶ 폭죽, 태권도 격파용 송판(폭죽 장착)의 경우 반입불가
- 폭발물 및 인화성 물질로 분류되어 휴대(기내로 가지고 가는 짐) 및 위탁(부치는 짐) 수하물 탑재가 모두 불가능합니다.
- 가스 및 가스용기(부탄, 스프레이페인트, 에어로졸, 살충제등), 딱성냥, 알코올 등을 포함한 인화성 물질은 휴대 및 위탁수하물이 모두 불가능.
- 소형안전성냥 또는 라이터는 1인당 1개만 소지가 허용
※ 딱성냥(마찰성냥), 대형 곽성냥은 휴대 및 위탁수하물 모두 반입 불가능

11. 보안 요원 채용에 관한 문의
Inquiries regarding hiring security guards

▶ 인천국제공항 보안 요원은 경비, 검색 분야로 구분
: ㈜인천국제공항보안에서 담당 각 분야마다 채용 시기 및 방법이 상이하기에 담당회사로 직접 문의하시기 바랍니다.

12. 이유식, 분유 등 유아용품 관한 문의
Inquiries regarding baby products such as baby food and powdered milk

▶ 유아는 만 6세 미만의 취학 전 아동을 말합니다.
- 앞서 언급했듯이 이유식, 분유, 주스, 물티슈 등은 액체 및 젤류 규정이 미적용됨
: 비행기 여정만큼의 분량만 허용됩니다.
- 1L 지퍼락 투명비닐봉지에 넣을 필요 없이 보안 검색 시 보안 요원 확인 후 직접 휴대하여 기내 반입이 가능합니다.

13. 화학물질(실리콘 등)에 관한 문의
Inquiries regarding chemicals (silicon, etc.)
▶ 실리콘 등의 경우는 유해성 물질로 분류되어 휴대(기내로 가지고 가는 짐) 및 위탁(부치는 짐) 수하물로 반입이 일부 제한
- 화학물질의 경우 항공기에 탑재가 가능한지 여부는 해당 항공사 담당자가 판단 후 반입.
- 화학물질의 경우 안전보건공단에서 제공하는 물질안전보건자료(MSDS : Material Safety Data Sheets)를 제시
: 안전성 확인 후 항공기 탑재가 가능한 것에 한하여 위탁수하물(부치는 짐)로 보냄.

14. 고감도 필름은 어떻게 보안검색을 하나요?
How is high-sensitivity film subject to security screening?

▶ 필름의 경우 개봉검색 또는 증명서류 확인 및 폭발물흔적탐지장비에 의한 방법으로 보안검색가능
: 단, 검색장비 등에 의하여 보안검색을 하는 경우 본래의 형질이 손상되거나 변질될 수 있는 것은 국토교통부장관의 허가를 받은 후 검색요원에게 공문을 제시해 주시면 보안검색을 면제받을 수 있습니다.

15. 국내선은 액체류 휴대가 가능한가요?
Is it possible to carry liquids on domestic flights?

▶ 액체류 기내반입 제한은 국제선에서만 규정을 적용, 국내선은 액체류 기내 반입 가능합니다.
※ 단, 인천-부산 내항기 환승 검색 시에는 국제선에 해당되므로 액체류 규정에 적용되어 기내반입을 제한하고 있습니다.
해외여행 출국심사 시 미리 알아야 할 기본정보와 유의사항을 상세하게 알아보시려면 아래 링크를 클릭해 보세요.
해외여행 출국심사시 미리 알아야 할 기본정보 및 유의사항
해외여행을 가기 위해서는 공항에서 출국심사를 받아야 하는데 이에 대한 기본정보와 유의사항을 상세히 소개하려 합니다.출국 시 가장 많이 묻고, 많이 알아야 할 내용들로 정리를 해 보았는
bewall2401.com
해외출국 전 초보 여행자들의 스마트한 인천공항 탑승수속을 상세하게 알아보시려면 아래 링크를 클릭해 보세요.
해외출국 전 초보 여행자들의 스마트한 인천공항 탑승수속 상세정보
해외여행, 출장등을 위해서는 인천공항 터미널을 통한 탑승수속을 밟아야 하는데 이에 대한 정보를 상세하게 소개하려 합니다.해외로 여행, 출장, 기타 사유로 나가려 하시는 분들을 위해 인천
bewall2401.com
'해외여행 기본정보' 카테고리의 다른 글
| 해외여행 입국시 입국심사중 미리 알아야 할 기본정보 및 유의사항 (39) | 2024.08.01 |
|---|---|
| 해외여행 출국시 탑승수속중 미리 알아야 할 기본정보 및 유의사항 (53) | 2024.07.28 |
| 해외여행 출국심사시 미리 알아야 할 기본정보 및 유의사항 (32) | 2024.07.19 |
| 해외출국 전 초보 여행자들의 스마트한 인천공항 탑승수속 상세정보 (44) | 2024.07.13 |
| 해외여행 귀국시 인천공항에서 송정, 염창역, 강남고속버스터미널 방면 심야 리무진버스(N6000) 상세정보 (35) | 2024.06.24 |